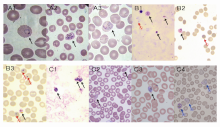

作者简介:田 斌,男,1982年生,主管技师,主要从事病原微生物学及分子生物学检测。
分析3例输入性疟疾的实验室诊断,减少卵形疟的误诊与漏诊。
方法采用形态学检查、巢氏聚合酶链反应(PCR)及序列分析等方法确诊3例输入性疟疾病例。
结果3例患者形态学检查结果分别是未检出疟原虫(实验室初次检查)、检出卵形与恶性疟原虫和检出卵形疟原虫;巢氏PCR检测结果依次是卵形疟原虫感染、卵形与恶性疟原虫混合感染和卵形与间日疟原虫混合感染。
结论需加强疟疾消除地区疟原虫形态学检查技术的培训和推广。应用分子生物学检查技术可减少输入性卵形疟的误诊与漏诊。
To analyze 3 cases of imported malaria infection, in order to reduce the misdiagnosis and missed diagnosis of ovale malaria infection.
MethodsBy morphological test, nested polymerase chain reaction (PCR) and sequence analysis were used to confirm the 3 cases of imported malaria infection.
ResultsThe morphological test results showed no plasmodium (laboratory initial inspection), plasmodium ovale mixed infection with plasmodium falciparum and plasmodium ovale. However, plasmodium ovale, plasmodium ovale mixed infection with plasmodium falciparum and plasmodium ovale mixed infection with plasmodium vivax were detected by nested PCR by follow.
ConclusionsThe morphological technique training and the application of molecular biology techniques should be strengthen for imported plasmodium ovale malaria infection, and can reduce the misdiagnosis and missed diagnosis of imported plasmodium ovale malaria infection.
卵形疟原虫(plasmodium ovale)是感染人类的疟原虫,首次发现最有可能是在1900年[ 1]。因其感染患者具有间日发热等特点,一直被认为是间日疟原虫(plasmodium vivax)的变种,直到1922年Stephens[ 2]才对该种疟原虫进行了完整的形态描述和命名。目前其地理分布局限在热带非洲、中东、巴布亚新几内亚、印度尼西亚的西伊里安查亚省和东南亚地区[ 3]。我国对卵形疟的报道极为鲜见。随着国际间交流的不断扩大与加深,输入性疟疾病例的数量也呈逐年增加的态势[ 4],给国内大部分疟疾消除地区的实验室诊断工作提出了新的挑战。我们分析了3例输入性卵形疟的实验室诊断,以提示检测人员应警惕卵形疟的误诊与漏诊。
标本为3例输入性卵形疟患者的静脉抗凝血,制作厚薄血膜涂片后-70 ℃冻存备检。病例情况如下:患者A,男,44岁,刚果(布)务工,2012年1月18日回国,回国至本次发病期间无外出史,本次发病日期2012年4月25日,症状为畏寒、发热(39.9 ℃,不规则)、发冷伴腹泻。该患者曾于2011年4月在刚果(布)发病,境外医疗机构未进行实验室检查,予青蒿素类注射剂治疗3 d后症状消失;患者B,男,22岁,塞拉利昂务工,2012年12月4日回国,回国至本次发病期间无外出史,本次发病日期2012年12月27日,症状为发热(38.4 ℃,不规则)、发冷、出汗,曾于2012年6月在境外出现类似症状,未行实验室检查,予青蒿素类注射剂治疗3 d后症状消失;患者C,男,25岁,尼日利亚黑人,发病前3周入境,于2012年12月31日发病,症状为发热且时间不规则,否认既往患过疟疾。
Giemsa染液为实验室自配;DNA提取试剂为QIAamp DNA Micro Kit;聚合酶链反应(PCR)扩增试剂为Invitrogen公司Platinum PCR SuperMix;显微照相系统购自德国Leica公司;PCR扩增仪购自美国ABI公司;电泳仪和凝胶成像系统为英国SYNGENE公司产品。
1. 厚、薄血膜涂片检查 按张进顺等[ 5]描述的方法进行制作厚、薄血膜涂片,行Giemsa染色后显微镜检查并照相。
2. 核酸扩增及序列分析 采用巢氏PCR对疟原虫18S rRNA基因进行扩增,按文献[ 6, 7, 8]提供序列由Invitrogen公司合成引物,见表1。第1轮扩增体系为上下游引物(10 μmol/L)各1 μL,Platinum PCR SuperMix 18 μL,DNA模板5 μL,计25 μL体系;第2轮扩增体系为上、下游引物(10 μmol/L)各1 μL,Platinum PCR SuperMix 16 μL,以第1轮反应产物1 μL作为模板,补去离子水至25 μL,各种特异性引物分别加入体系,不共用体系。扩增条件第1轮和第2轮相同,均为95 ℃ 5 min,1个循环;94 ℃ 30 s,58.5 ℃ 30 s,72 ℃ 90 s,36个循环;72 ℃ 5 min,1个循环;4 ℃,∞。扩增完成后对第2轮扩增产物进行琼脂糖电泳检测。产物测序由宝生物工程(大连)有限公司完成。
| 表1 巢氏PCR扩增18S rRNA基因引物序列 |
厚血膜中卵形疟原虫除滋养体以外各期原虫均为圆形或卵圆形;数目不等的细胞核较为明显,呈紫红色;细胞质浓郁,呈深蓝色;偶见红色较粗大的红色薛氏点(Schuffner's dot)和黄棕色的疟色素。薄血膜中,被卵形疟原虫寄生的红细胞可呈卵圆形、梭形或泪滴形;略胀大;边缘不整齐呈锯齿状或一端似扫帚状等。滋养体阶段细胞核粗大明显呈紫红色;胞浆粗壮,可有空泡,亦可出现阿米巴样伪足;裂殖体阶段虫体呈圆形或卵圆形,细胞核呈分裂状,成熟的裂殖体一般含有612个裂殖子排列成环状或不规则串状。配子体阶段虫体呈圆形或椭圆形;胞浆均匀;细胞核1个,位于虫体的边缘或中央。薛氏点可存在被各阶段原虫寄生的红细胞内,包括早期滋养体,较明显。疟色素呈黄棕色粒状或短杆状;常出现在成熟滋养体及以后各发育阶段,随虫体的发育量增加;在裂殖体阶段集中,在配子体阶段相对分散。见图1。
患者A为卵形疟原虫感染;患者B为卵形、恶性疟原虫混合感染;患者C为卵形、间日疟原虫混合感染。见图2。
本研究对患者A卵形疟原虫特异性条带进行了测序。由于采用的是巢氏PCR产物进行测序,存在产物不单一情况,遂取中间无套峰的600 bp(见图3)采用NCBI Blast工具进行比对,比对结果显示与Sequence ID: gb|HQ697267.1/gb|HQ697266.1/dbj|AB182490.1等卵形疟原虫18S rRNA基因序列的同源性为100%。
本研究所检出的3例卵形疟患者的输入地均为非洲中西部有卵形疟原虫流行的国家[ 9, 10, 11],其中2例患者在国外有疟疾的既往史,另1例患者为疟疾流行区居民。患者A薄血膜(首诊医疗机构未制作厚血膜)初次检查结果为未检出疟原虫,但由于其具有疟疾流行病学史和临床表现,因此对其标本进行了巢氏PCR扩增,当结果为阳性时,回顾阅片时才发现确有卵形疟原虫的滋养体和裂殖体,出现首次形态学检查假阴性可能与患者带虫密度较低和镜检人员不熟练有关;患者B的厚、薄血膜上,具有形态学上非常典型的卵形和恶性疟原虫形态,不容易产生漏诊,两种检查方法结果一致;患者C形态学检查结果较巢氏PCR漏诊了间日疟原虫的感染,由于间日疟原虫和卵形疟原虫形态上的相似,使得此类混合感染的诊断极为困难,需仔细检查才可以避免。可见疟原虫显微镜检查方法的局限性、混合感染及罕见虫种(卵形疟在疟疾流行最为严重的非洲其感染患者占疟疾病例的比例也很少超过10.5%[ 12],中国则无本地感染病例,输入性的卵形疟也罕见)的出现使输入性疟疾的实验室诊断具有一定难度。目前国内在疟疾实验室诊断上具有丰富经验的检验人员断档,也是输入性疟疾病例漏诊和误诊的原因之一[ 13, 14, 15, 16]。因此应当加强疟疾消除地区疟原虫形态学检查技术培训,推广分子生物学检查技术的应用,减少输入性卵形疟实验室检查的误诊与漏诊。
卵形疟原虫虽在形态上同间日和三日疟原虫有一定的区别,但这种区别不仅需要阅片经验,同时还受药物、血标本类型及操作等多种因素影响。被寄生红细胞胀大与否及胀大程度是卵形疟与三日、间日疟原虫鉴别要点,但细胞胀大是相对的,当采用不新鲜抗凝标本时这种相对胀大就很难发现;红细胞边缘形态也是鉴别点之一,也会受制片和渗透压等因素影响,这种影响甚或导致判断错误;薛氏点、齐氏点和疟色素等受标本新鲜度和染色质量的影响更大,标本陈旧、染色不佳时可能根本无法观察到这些特点;裂殖子的数目和排列形态及疟原虫胞浆的特点虽也可作为上述3种疟原虫鉴别的要点,但其之间存在不同程度的交叉(裂殖子数目:间日疟原虫12~24个,卵形疟原虫和三日疟原虫为6~12个;胞浆空泡3种疟原虫均可出现,间日疟原虫和卵形疟原虫还可出现伪足)。
一般认为卵形疟原虫的潜伏期为10~17 d,发作症状较轻,很少复发,多在6~10次发作后自愈[ 3],这可能与卵形疟原虫仅感染网织红细胞,其原虫血症一般限制在2%5%的红细胞内[ 17]有关。而本研究中患者A在无疟疾流行区居留时间远远超过潜伏期。因此,该患者可能是复发病例,也不排除少数卵形疟潜伏期更长,或该患者期间有过疟疾发作,由于症状较轻而被忽视的可能。患者C为卵形和间日疟原虫的混合感染。间日疟在红细胞膜上的受体是Duffy血型抗原。而西非黑人和美国黑人Duffy血型阴性[ 18],缺少间日疟受体决定簇,故间日疟原虫不能侵入这类红细胞寄生,可以说Duffy血型阴性的人群对间日疟原虫存在天然抵抗[ 3]。因此,在西非黑人似乎不应该存在卵形和间日疟原虫的混合感染。所以患者C的Duffy血型及产生此类混合感染的现象值得进一步研究。而Purnomo等[ 19]曾报道1例四重疟疾感染的病例和在疟疾高度流行区域健康带虫者同时感染3~4种疟原虫并不罕见的事实又使卵形和间日疟原虫的混合感染可以解释。
联合国千年发展目标提出在全球根除疟疾倡议。卫生部等13部委制定和颁布了“中国消除疟疾行动计划(20102020年)”。加强疟疾消除地区疟原虫形态学检查技术培训及推广分子生物学检查寄生虫技术的应用,减少输入性卵形疟实验室检查的误诊与漏诊十分必要。
| [1] |
|
| [2] |
|
| [3] |
|
| [4] |
|
| [5] |
|
| [6] |
|
| [7] |
|
| [8] |
|
| [9] |
|
| [10] |
|
| [11] |
|
| [12] |
|
| [13] |
|
| [14] |
|
| [15] |
|
| [16] |
|
| [17] |
|
| [18] |
|
| [19] |
|